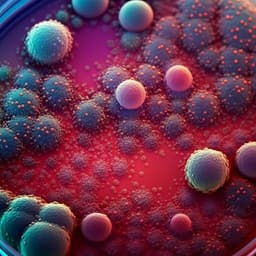

Environmental Studies and Forestry
Feeding climate and biodiversity goals with novel plant-based meat and milk alternatives
M. Kozicka, P. Havlik, et al.
Animal source foods (ASFs) provide less than 20% of global dietary energy but drive the majority of land use, water use, biodiversity loss, and GHG emissions from food systems. While higher ASF intake can improve nutrition in low-income settings, overconsumption of red and processed meats is linked to adverse health outcomes, and ASF demand is projected to grow globally. Encouraging lower-ASF diets is seen as essential for climate mitigation, health, food security, and staying within planetary boundaries, yet widespread shifts are challenging. Novel plant-based alternatives for meat and milk that mimic sensory attributes offer a behaviorally viable pathway to reduce ASF consumption. Existing macro-level analyses are limited in scope, scale, or impact coverage. This study addresses the gap with a comprehensive, dynamic, system-wide global assessment of substituting key ASFs (beef, pork, chicken, milk) with nutritionally equivalent plant-based alternatives, evaluating implications for GHG emissions, land use, biodiversity, food prices, and food security to 2050.
The paper situates its contribution within literature showing: (1) high environmental burdens from ASFs relative to their caloric contribution; (2) health risks associated with high red/processed meat intake; (3) projected increases in ASF consumption; and (4) the importance of dietary shifts for meeting climate and biodiversity targets. Prior dynamic macro-level studies of novel alternatives were few and limited—either geographically or by considering a narrow set of impacts or market developments. Local LCA studies show environmental benefits of plant-based alternatives, but system-wide effects in a globally connected food system remained underexplored. The study builds on SSP2-aligned projections and contemporary evidence on diet trends (e.g., flexitarian rise, limited vegan adoption) and references that beef substitution yields outsized environmental gains compared to other meats in prior work.
The authors use the Global Biosphere Management Model (GLOBIOM), a partial-equilibrium model integrating global agriculture, bioenergy, and forestry, solved recursively in 10-year steps (2000–2050). The reference scenario (REF) follows SSP2 ('middle-of-the-road') socioeconomics with constant policies and assumes current climate without exogenous climate shocks. Food demand depends on population, income, and price response; trade is modeled across 37 economic regions; the crop sector includes 18 major crops and the livestock sector covers 7 animal products with heterogenous production systems. AFOLU GHGs include N2O (fertilizer/manure), CH4 (enteric fermentation, manure management, rice), and CO2 from land-use change. Nitrogen flows follow Chang et al.; water use and biodiversity are tracked, with biodiversity measured via the Biodiversity Intactness Index (BII) using the PREDICTS-based model with recovery dynamics (Poorter et al.). Scenarios: ASF substitution levels of 10%, 25%, 50%, and 90% by 2050, starting post-2020 and phased in linearly from 2030 to 2050. Substitution applies globally or to one of 13 macro-regions. Products substituted: beef, pork, chicken, milk—either individually (with exogenously chosen recipe) or simultaneously (model endogenously selects least-cost recipe by region). Novel alternatives are modeled via crop input 'recipes' nutritionally equivalent to their animal analogs, ensuring macro- and micronutrient parity and protein quality (AAS ~0.9–1.0; milk M2 requires supplementation). Recipes include proteins, binders (carbohydrates), and oils; five beef recipes and two for each of chicken, pork, milk are specified. Ingredients are translated to primary crop equivalents using processing yields; two processing assumptions: inefficient (all primary input allocated to ingredient) and efficient (co-products utilized, reducing primary crop requirement). Sourcing variants: global (no import caps) vs local (imports capped at REF levels per macro-region). The model assumes 1:1 substitution in consumption between ASF and novel alternatives, with production costs of novel alternatives other than crop inputs not modeled. Land restoration: Afforestation of abandoned agricultural land within former forest ecosystems is optionally modeled using G4M to estimate afforestation potentials and carbon sequestration, with locally native species. Restoration timing and BII recovery lags are accounted for. Additional considerations: animal fats substitution is not modeled; nutritional profiles mirror regional ASF calories; GLOBIOM’s partial-equilibrium scope excludes broader economy sectors.
- In REF (no plant-based transition), 2020–2050: agricultural area +4% (+219 Mha), forest and other natural land −5% (−255 Mha), cropland nitrogen input +39% (+59 Mt), water use +6% (+197 km³), AFOLU GHG +15% (+1.1 Gt CO2eq/yr), BII −2.1%.
- At 50% substitution by 2050 (global, all products, inefficient processing):
- Land and inputs: global agricultural area declines 12% vs 2020; 653 Mha land is released. Forest and other natural land is only 1% below 2020 (deforestation largely halted). Nitrogen inputs increase far less than REF (+34 Mt vs 2020), with total cropland N input 27.8 Mt lower vs REF; water use −10% (−291 km³) vs 2020.
- Emissions: AFOLU GHG emissions decline by 2.1 Gt CO2eq/yr (−31%) in 2050 vs 2020 (average −1.6 Gt CO2eq/yr over 2020–2050) without counting sequestration on spared land.
- Prices and food security: animal product prices −14.1%; crop prices −4.9%. Global undernourishment declines modestly to 3.6% in 2050 (−31 million vs REF), with largest absolute improvements in Sub-Saharan Africa (−17 million vs REF).
- Processing efficiency: assuming efficient co-product use reduces crop needs for alternatives by ~60% vs inefficient scenarios; system-wide outcomes change little at low substitution rates and become more pronounced at high rates (crop use up to 8% lower).
- Nonlinearities: beyond ~50% substitution, additional deforestation and land-use CO2 reductions saturate as conversion of natural land ceases; higher substitution increases land abandonment.
- Adding land restoration (afforestation of spared land in former forests):
- At 50% substitution: additional carbon removals reach 3.3 Gt CO2/yr in 2050 (1.5 Gt CO2/yr average 2020–2050), more than doubling climate benefits; total AFOLU emissions reduction 6.3 Gt CO2eq/yr vs REF in 2050 (~92% of previously estimated land-sector mitigation potential without BECCS). At 90% substitution, total reductions reach 11.1 Gt CO2eq/yr in 2050 (11.9 Gt vs REF).
- Biodiversity: BII decline reduced to −0.9% (50%) and −0.3% (90%) by 2050 vs −2.1% in REF; biodiversity loss reversal achieved between 2030–2040 at 90%. Restored land by 2030: +204 Mha (50%) and +464 Mha (90%), meeting 58% and 133% of the 350 Mha Bonn Challenge, and 13–25% (50%) or 29–57% (90%) of the 810–1620 Mha restoration needs to meet Kunming–Montreal GBF Target 2 (assuming 20–40% degraded).
- Regional distribution (50% scenario): China accounts for ~25% of global cropland abandonment (~20.7 Mha), ~22% of direct agricultural non-CO2 reduction (−0.5 Gt CO2eq/yr), ~20% of global water (−139 km³) and nitrogen (−5.4 Mt) input reductions. Sub-Saharan Africa achieves the largest avoided forest/natural land loss (−76.6 Mha vs REF; ~37% of global), and the largest land-use change CO2 reductions (−0.4 Gt CO2/yr; ~47% of global). Sub-Saharan Africa, Brazil, and Other South America hold the largest shares of spared/restored land and corresponding sequestration; together these three regions deliver ~51% of global GHG reductions in 2050 despite lower consumption shares of novel alternatives. BII benefits are largest in Sub-Saharan Africa, China, and Southeast Asia (2–2.1 percentage points less decline vs REF).
- Product-specific effects: Beef substitution drives roughly half of total GHG, land-use, and biodiversity benefits; pork and chicken substitution free more cropland (notably in China). Substituting all products simultaneously yields synergistic effects exceeding the sum of single-product substitutions.
- Market dynamics: Single-region substitution yields smaller local impacts than global substitution due to ongoing export demand and rebound effects (lower prices increase consumption elsewhere).
The study demonstrates that replacing half of global beef, pork, chicken, and milk consumption with nutritionally equivalent plant-based alternatives can reverse key pressures: it eliminates most land-use change from these commodities and cuts AFOLU emissions by nearly a third relative to 2020, with substantial methane reductions that aid near-term climate goals. Additional land restoration more than doubles mitigation, approaching the land-sector abatement consistent with a 1.5 °C pathway without BECCS, while also significantly reducing biodiversity loss and contributing meaningfully to global restoration targets. Benefits saturate beyond 50% substitution for deforestation and land-use CO2 because agricultural expansion halts at that threshold; however, higher substitution expands land abandonment, offering greater restoration opportunities. Regional heterogeneity reflects differences in diets, production systems, productivity, and trade: China’s demand patterns drive large input reductions; Sub-Saharan Africa and South America deliver outsized land-use and emissions benefits due to extensive systems and export roles. Product targeting matters—beef yields the largest climate and land benefits, while multi-product strategies provide synergies. Realizing full benefits depends on land-use policies that channel abandoned land into ecologically appropriate restoration; without such measures, land could be reallocated to other agricultural uses. The study also highlights rebound effects (lower prices undermining some gains) and underscores the need for coordinated demand- and supply-side interventions, as well as policies that ensure equitable transitions for producers and communities. Given plausible market trajectories (price parity and adoption of alternative proteins), a 50% substitution is argued to be realistic, and faster adoption would enhance benefits.
A system-wide, dynamic global analysis indicates that substituting 50% of major ASFs with novel plant-based alternatives by 2050 can nearly halt deforestation from these commodities, reduce AFOLU emissions by 31% (without restoration), and—with restoration of spared agricultural land in former forests—achieve mitigation close to the land-sector potential aligned with 1.5 °C, while substantially improving biodiversity outcomes and contributing to global restoration targets. Synergistic substitution across multiple products and targeted regional strategies can amplify benefits. Policy frameworks are crucial to steer abandoned land toward restoration, manage rebound effects, safeguard livelihoods, and accelerate adoption through information, standards, procurement, and pricing reforms. Future work should integrate broader socio-economic dimensions (employment, livelihoods, cultural roles), explicitly model alternative protein market development and costs, assess nutrition-health outcomes across populations, examine non-forest ecosystem restoration, and consider climate change impacts on yields and productivity within coupled human–natural systems.
- Modeling scope: GLOBIOM is a partial-equilibrium model; broader macroeconomic feedbacks (employment, income, sectoral shifts) are not captured. Agricultural policy settings are held constant; changes could alter outcomes.
- Climate assumptions: current climate is assumed; no exogenous climate impacts on yields or productivity are applied, potentially underestimating future food security risks and system stresses.
- Substitution mechanics: assumes 1:1 substitution between ASF and plant-based alternatives with exogenously imposed adoption; production costs, prices, consumer preferences, and market dynamics of novel alternatives are not modeled.
- Processing and co-products: outcomes are sensitive to processing efficiency assumptions; real-world utilization of by-products varies. Ingredient processing yields and co-product markets introduce uncertainty.
- Nutritional scope: recipes match macronutrients and amino acid profiles (AAS 0.9–1.0; milk M2 requires supplementation), but digestibility adjustments and full micronutrient bioavailability are not explicitly modeled.
- Product system boundaries: substitution of animal fats is not modeled; non-forest ecosystem restoration pathways are excluded, likely underestimating potential biodiversity benefits in some regions.
- Rebound and extensification: lower prices can induce consumption rebounds elsewhere; reduced livestock prices may lead to extensification, lowering average productivity and increasing emissions intensity.
- Trade and sourcing: local vs global sourcing constraints are stylized (import caps at REF levels for local scenarios); final-product trade of alternatives is not modeled, which could alter trade flows and regional impacts.
Related Publications
Explore these studies to deepen your understanding of the subject.